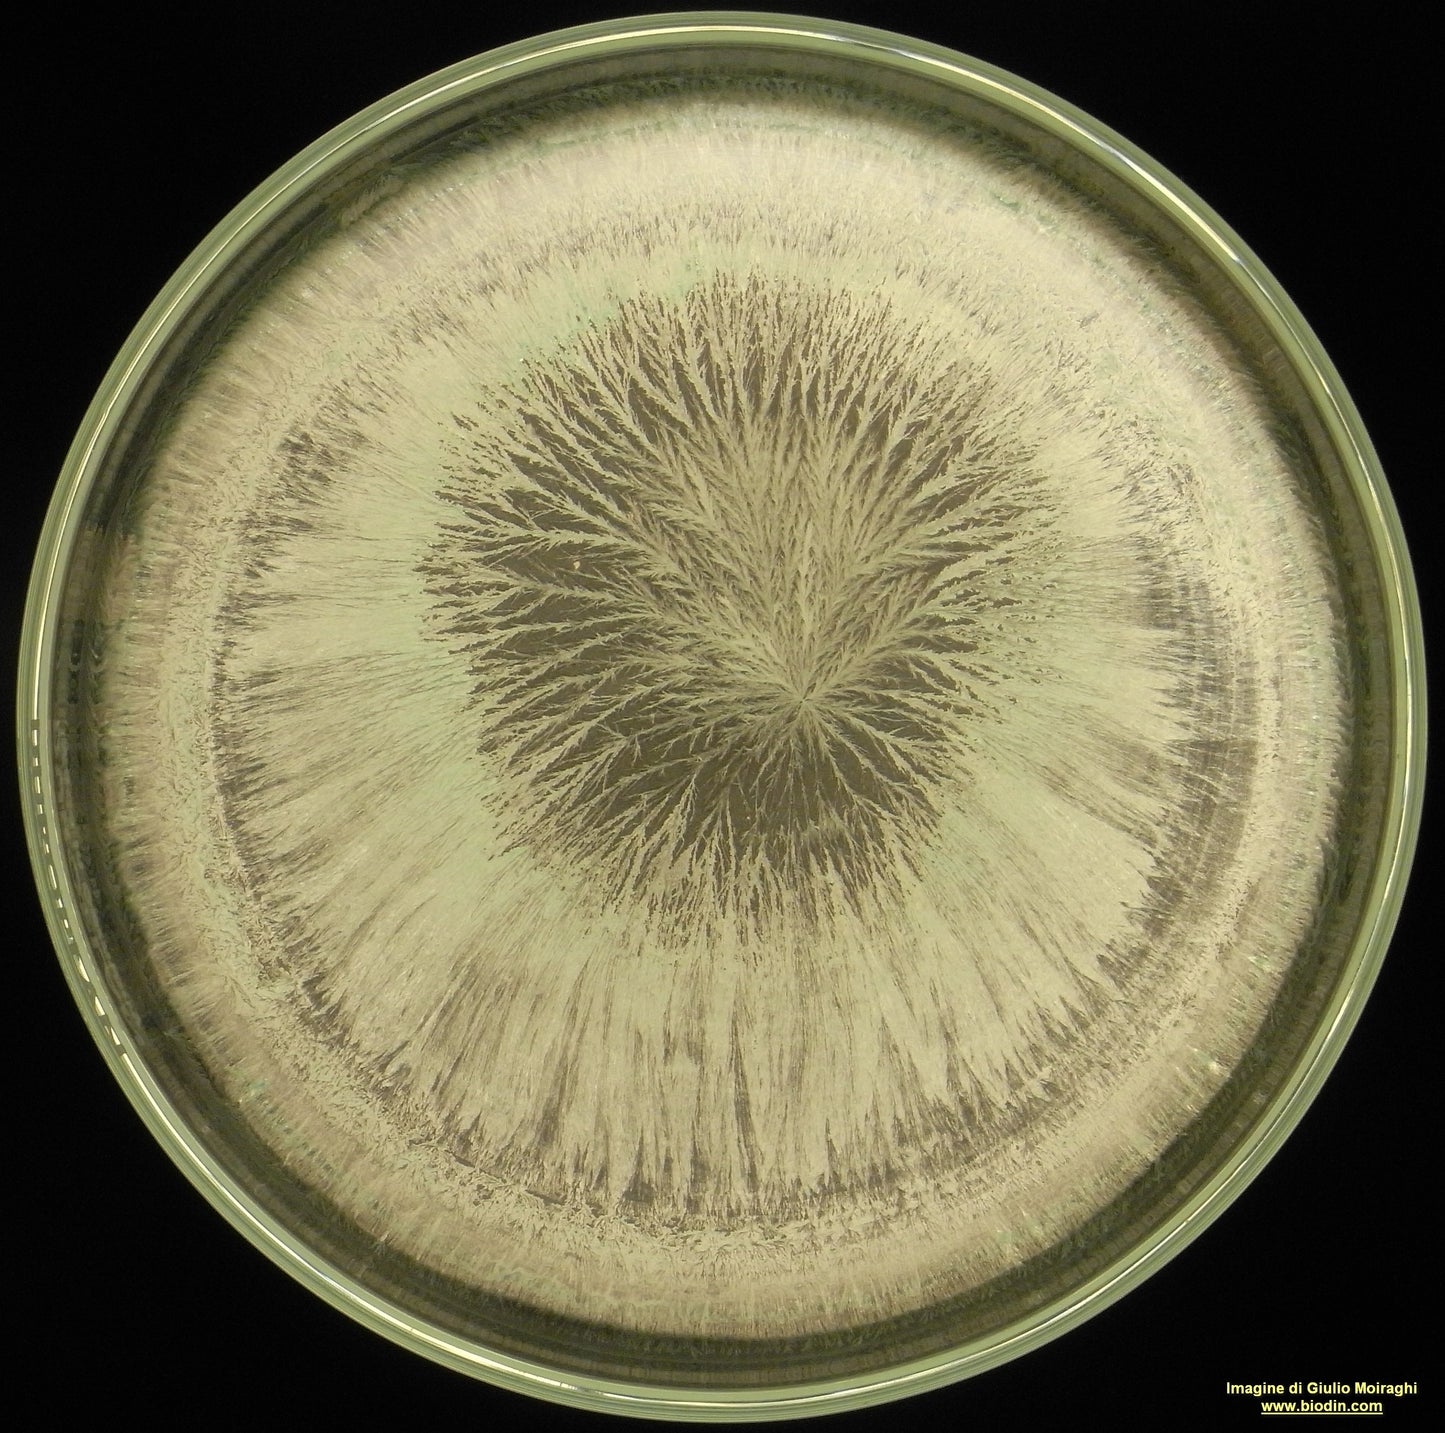

526 CORNO LEGNO FOSSILE
Have a question?

526 CORNO LEGNO FOSSILE
Dettagli
SCHEDA D'USO 526 CORNO LEGNO FOSSILE
Il corno legno fossile (526) è un preparato biodinamico che è stato a maturare per 18 mesi.
Il legno fossile è uno stabilizzatore delle difese immunitarie e rafforza il corpo eterico della pianta.
In cristalloterapia si usa per gli arti atrofizzati e per alleviare le paralisi.
È un silicato (SiO2) come il quarzo che ha preso posto della struttura originaria del legno.
Si usa all’equinozio di primavera (21 marzo) o due giorni prima della Luna Piena per riequilibrare e rafforzare il corpo eterico delle piante a legno o piante annuali deboli oppure nel periodo del segno del Capricorno (19 gennaio -15 febbraio).
Rafforza le difese immunitarie, protegge le piante dalle avversità (funghi e batteri) e rinvigorisce il cambio
Usarne 30 grammi per ettaro dinamizzato in 40-50 litri di acqua per 60 minuti e spruzzato al mattino a goccia fine sul legno o sulle piante
Presso Agri.Bio potrete trovare:
• Pezzi di legno fossile
• Libro “Tratto sul legno fossile” di Francesco Stelluti